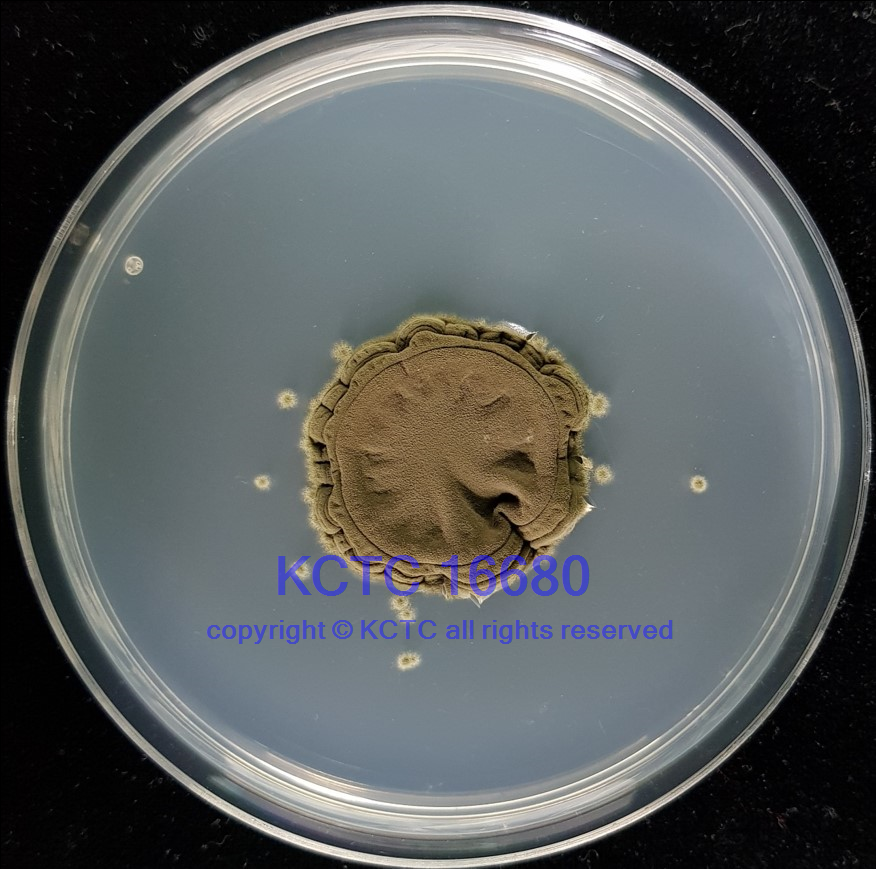

KCTC No. 16680
(KCTC Other No.)
Resource Type Mold
Name Cladosporium cladosporioides
Type Strain No
Biosafty Level 1
LMO No
Synonym
Phylum (ex Phylum)
Genome Information
History <- K.S. Bae <- Lotte
Source From pie (contaminated on food stuff)
Other Collection No.
Reference
KCTC Media No. KCTC media No. 31 Malt Extract Agar (Blekeslee's Formula)
Oxygen Requirement Aerobic
Temperature 25 ℃
pH netural pH ?? ?? (???? ??)
KCTC16680